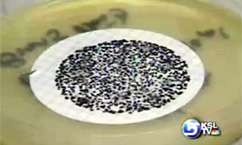
How Safe Are Pedicures?

Estimated read time: 3-4 minutes
This archived news story is available only for your personal, non-commercial use. Information in the story may be outdated or superseded by additional information. Reading or replaying the story in its archived form does not constitute a republication of the story.
Debbie Dujanovic Reporting They're cheap, fast, and popping up all over the place. But are they safe?
"Should women be afraid?"
"Oh, I wouldn't allow a family member or a friend to put their foot in a bath like this."
Before you make your next pedicure appointment, see what our investigation uncovered. We found so much contamination, it would be enough to shut down a hospital. What about a nail salon?

With a growing number of shops promising fast service at a great price, we stopped in for some pedicures.
Summer toes are the hot thing. Twenty dollars; done in an hour.
Maybe:
"My toenails just turned yellow and started crumbling."
Penny Webster: "Green. Your two big toes actually turned green. Green. My two big toes were green and the rest of my toes turned white."
There's Penny Webster's infected toes and fingernails.
"They started to feel peculiar. I was pushing on it and I took a hold of it, went like that, and the whole thing came off."

And Lee Anne Edwards:
"It just looked awful."
Her $20 pedicure:
"I only had this much toe nail left that was even normal."
Now $900 to fight an infection.
Dr. Mark Moritz/St. Mark's Hospital: "I've seen a big increase, yeah."
Dr. Mark Moritz is a podiatrist at St. Mark's Hospital.
Dr. Moritz: "Somebody could potentially die from something like this. And that's what's very scary. They may not know where it came from."
We listened to doctors who say nail salons are putting more women at serious risk for infections. You'll be amazed at what we found. A surprising number of salons violate regulations. That you're being exposed to outrageous levels of bacteria. And,it's up to you to protect yourself.
We sent women into five salons we chose at random. All had recently passed a county health inspection. We collected water samples from jetted pedicure tubs.
We delivered the samples to a lab. The testing started. Bacteria began to grow, and grow.
While we waited, we analyzed 70 health inspections. Inspectors cited safety problems at more than half the salons they went in to.
Pedicure tools not disinfected between clients, dirty floors, clippers with old nail shavings left on them. Dirty files getting reused.
Dr. Moritz: "This is awful."
Our water tests uncovered another hazard.
Dr. Moritz: "I wouldn't let my mother, my sister, my friend go to a facility that had this kind of bacteria count."
Ten different forms of bacteria, in four of the five pedicure basins we tested. They include staph, klebsiella, pseudomonas known to cause: tissue damage, gangrene. In fact, doctors say they have amputated toes, removed nails, from exactly such infections.
Dr. Moritz: "It indicates to me that many people have used the same bath without a cleaning in between it."
Our tests found bacteria colonies 11-hundred times greater than what's considered safe.
The doctor considers three very dangerous. But: 34-thousand bacteria colonies:
"This would say to me that somebody needs to be shut down."
At the Salt Lake Valley health department, inspectors say they won't shut them down.
"Buyer beware."
And you're on your own.
They don't test for contamination. There are no standards for pedicure water. You should ask questions if it seems dirty:
Diane Keay/ Salt Lake Valley Health Dept.: "I wouldn't just turn around and leave. I would tell them why I am turning around and leaving."
We didn't name the salons we tested -- they were chosen at random, to find out how widespread the problem is. Again, four out of five had contamination.
To show you how serious it is: KSL radio's Suzanne Viehweg had a pedicure, then a blood infection ran up her leg. Worst case scenario: a foot amputation. But, two months of treatment appear to be working.
Because of our investigation, the Salt Lake Valley Health Department issued new guidelines for consumers tonight.








